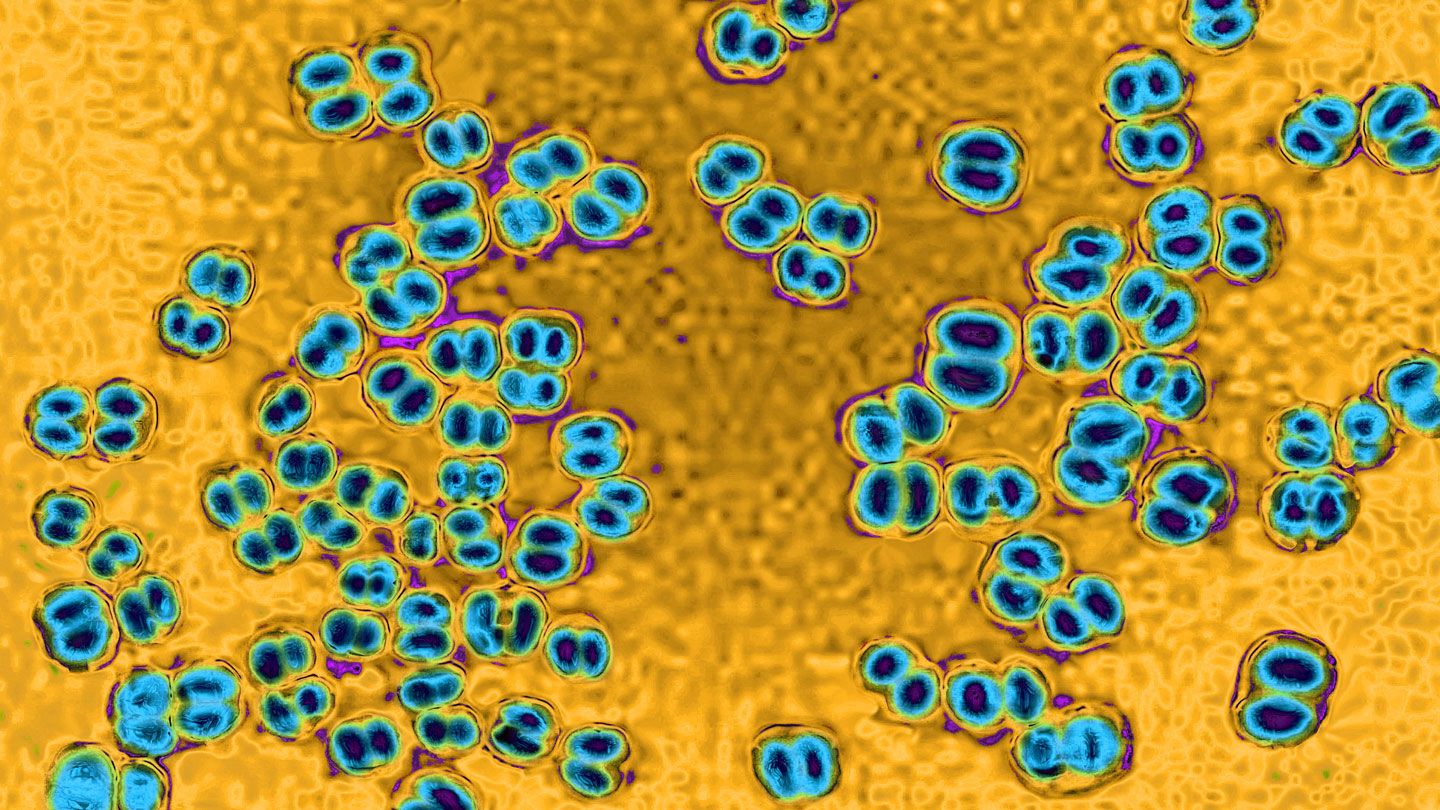

Sự gia tăng các trường hợp viêm màng não là mối lo ngại về bệnh truyền nhiễm mới nhất
15/04/2024
0
Sự gia tăng các trường hợp mắc bệnh viêm màng não do vi khuẩn đã khiến các quan chức y tế liên bang đưa ra cảnh báo về sức khỏe, cảnh báo các nhà cung cấp dịch vụ chăm sóc sức khỏe ở Hoa Kỳ phải cảnh giác với những người có triệu chứng của căn bệnh hiếm gặp nhưng có khả năng gây tử vong này.
Theo báo cáo của Trung tâm Kiểm soát và Phòng ngừa Dịch bệnh (CDC) Hòa Kỳ rằng 143 người trong nước đã bị nhiễm một chủng vi khuẩn não mô cầu xâm lấn hiếm gặp cho đến thời điểm này trong năm 2024 - tăng 62 trường hợp so với số lượng được báo cáo cùng kỳ năm ngoái. Trong số 94 bệnh nhân được biết kết quả từ năm 2023, 18% đã tử vong. Tỷ lệ tử vong này cao hơn mức lịch sử 11% được báo cáo từ năm 2017 đến năm 2021.
Vi khuẩn Neisseria meningitidis , được phóng đại 1.000 lần là nguyên nhân gây ra bệnh viêm màng não
Tiêm chủng đã kiểm soát được bệnh viêm màng não
Bệnh viêm màng não cầu khuẩn có thể được ngăn ngừa bằng vắc-xin, được khuyến nghị cho thanh thiếu niên từ 11 đến 12 tuổi và sinh viên năm nhất đại học chưa được tiêm chủng sống trong ký túc xá. Vì khả năng bảo vệ không còn nữa nên CDC khuyến nghị tiêm liều nhắc lại ở tuổi 16.
Vắc xin não mô cầu bảo vệ chống lại một số loại vi khuẩn khác nhau gây bệnh, bao gồm cả chủng bất thường ST-1466 gây ra nhiều bệnh nhiễm trùng gần đây. Thông tin chi tiết mới nhất của CDC không chắc chắn có bao nhiêu người nhiễm bệnh trong năm nay đã được tiêm chủng.
Việc giảm hút thuốc lá cũng có thể góp phần làm giảm độ nhạy cảm và giảm bệnh viêm màng não cầu khuẩn trong những năm gần đây.
Ai có nguy cơ mắc bệnh viêm màng não cao nhất?
Các quan chức y tế liên bang đã cảnh báo rằng sự gia tăng bệnh tật hiện nay đang ảnh hưởng không tương xứng đến những người từ 30 đến 60 tuổi, người Mỹ da đen và những người nhiễm vi rút suy giảm miễn dịch ở người (HIV) .CDC lưu ý rằng vì những người nhiễm HIV có hệ miễn dịch yếu nên tình trạng nhiễm trùng xảy ra thường xuyên hơn và nghiêm trọng hơn.
Mặc dù không rõ lý do tại sao căn bệnh này có nhiều khả năng ảnh hưởng đến người Mỹ da đen hơn, nhưng nghiên cứu đã gợi ý rằng đột biến gen phổ biến hơn ở nhóm này có thể khiến họ dễ bị nhiễm bệnh hơn.
Viêm màng não có lây không? Nó lây lan như thế nào?
Vi khuẩn não mô cầu lây lan từ người này sang người khác qua dịch tiết đường hô hấp và cổ họng (nước bọt hoặc nước bọt), thường là khi có tiếp xúc gần gũi (ví dụ: ho hoặc hôn). Bệnh cũng có thể lây truyền qua việc dùng chung đồ uống hoặc thuốc lá, thiết bị hút thuốc hoặc cần sa.
Thanh niên có thể dễ bị tổn thương hơn nếu họ đến quán bar, nơi có nhiều tương tác gần gũi, rất riêng tư với người khác, chẳng hạn như nói chuyện sôi nổi.
Tuy nhiên, CDC nhấn mạnh rằng bệnh viêm màng não cầu khuẩn không dễ dàng lây truyền qua tiếp xúc thông thường hoặc qua việc hít thở không khí ở nơi người mắc bệnh đã từng đến, chẳng hạn như bệnh cúm.
Các triệu chứng của viêm màng não là gì?
Các triệu chứng phổ biến nhất của bệnh viêm màng não cầu khuẩn là sốt, nhức đầu và cứng cổ, nhưng bệnh nhân cũng có thể bị buồn nôn, nôn, nhạy cảm với ánh sáng và lú lẫn.
Vi khuẩn này cũng có thể gây nhiễm trùng máu do não mô cầu, với các triệu chứng có thể bao gồm sốt và ớn lạnh, mệt mỏi, nôn mửa, tay chân lạnh, đau nhức dữ dội, thở nhanh, tiêu chảy và ở giai đoạn sau, phát ban màu tím sẫm.
Bệnh nhân bị nhiễm trùng máu hoặc viêm khớp nhiễm trùng (một bệnh nhiễm trùng khác do vi khuẩn não mô cầu gây ra, trong dịch khớp và mô khớp) đôi khi có thể không có dấu hiệu bệnh tật. Vi khuẩn viêm màng não này ở hầu họng và cổ họng mà người bệnh không hề biết, nên người ta cho rằng căn bệnh này thường lây lan từ một người không có triệu chứng.
Viêm màng não do vi khuẩn cần điều trị kịp thời
Nếu được phát hiện sớm, bệnh viêm màng não cầu khuẩn có thể được điều trị thành công bằng kháng sinh. Tuy nhiên, nhiễm trùng có thể tiến triển nhanh chóng và gây tổn hại cơ thể nghiêm trọng đến mức thuốc kháng sinh không thể ngăn ngừa các vấn đề nghiêm trọng lâu dài hoặc tử vong. Những người sống sót có thể phải chịu những ảnh hưởng lâu dài như điếc hoặc cắt cụt chi.
Khuyến khích những người có thể đã tiếp xúc gần với người bị nhiễm bệnh dùng thuốc kháng sinh như một biện pháp phòng ngừa.
Fanpage
Youtube


















